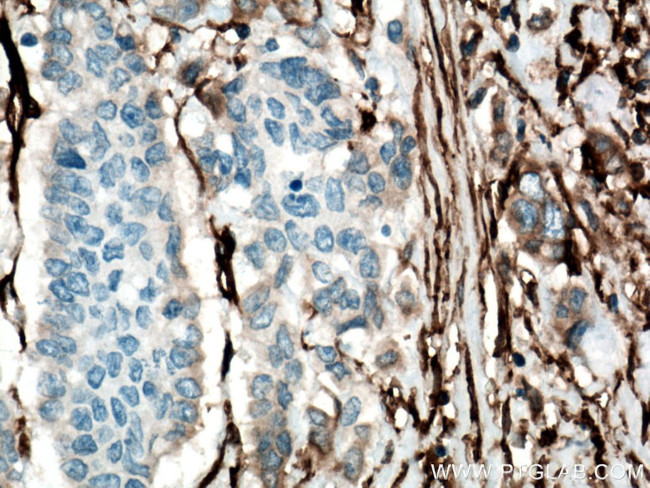
CD90 Antibody in Immunohistochemistry (Paraffin) (IHC (P))

Search
Proteintech
CD90 Monoclonal Antibody (2D7D11)
{{$productOrderCtrl.translations['antibody.pdp.commerceCard.promotion.promotions']}}
{{$productOrderCtrl.translations['antibody.pdp.commerceCard.promotion.viewpromo']}}
{{$productOrderCtrl.translations['antibody.pdp.commerceCard.promotion.promocode']}}: {{promo.promoCode}} {{promo.promoTitle}} {{promo.promoDescription}}. {{$productOrderCtrl.translations['antibody.pdp.commerceCard.promotion.learnmore']}}
产品信息
66766-1-IG
种属反应
宿主/亚型
分类
类型
克隆号
抗原
偶联物
形式
浓度
规格
纯化类型
保存液
内含物
保存条件
运输条件
产品详细信息
Immunogen sequence: QKVTSLTAC LVDQSLRLDC RHENTSSSPI QYEFSLTRET KKHVLFGTVG VPEHTYRSRT NF (20-80 aa encoded by BC065559)
靶标信息
CD90 (Thy 1) antigen is a GPI linked glycoprotein member of the Immunoglobulin super family. CD90 is expressed in murine T cells, thymocytes, neural cells, Kupffer's cells and fibroblasts. CD90 may play a role in cell-cell or cell-ligand interactions during synaptogenesis and other events in the brain. CD90 can be used as a marker for a variety of stem cells and for the axonal processes of mature neurons. Structural study of CD90 led to the foundation of the Immunoglobulin superfamily, of which it is the smallest member, and led to the first biochemical description and characterization of a vertebrate GPI anchor. Diseases associated with CD90 dysfunction include nasopharyngeal carcinoma and thymoma.
仅用于科研。不用于诊断过程。未经明确授权不得转售。
生物信息学
蛋白别名: CD90; CDw90; FLJ33325; membrane glycoprotein; Thy 1.2; Thy-1 antigen; thy-1 glycoprotein; Thy-1 membrane glycoprotein; Thy-1 protein; Thy-1 T-cell antigen; thymus cell antigen 1, theta; Thymus cell surface antigen; unnamed protein product
基因别名: CD7; CD90; CDw90; T25; Thy-1; Thy-1.2; THY1; Thy1.1; Thy1.2
UniProt ID: (Human) P04216, (Mouse) P01831, (Rat) P01830
Entrez Gene ID: (Rabbit) 100339279, (Pig) 100271931, (Human) 7070, (Mouse) 21838, (Rat) 24832